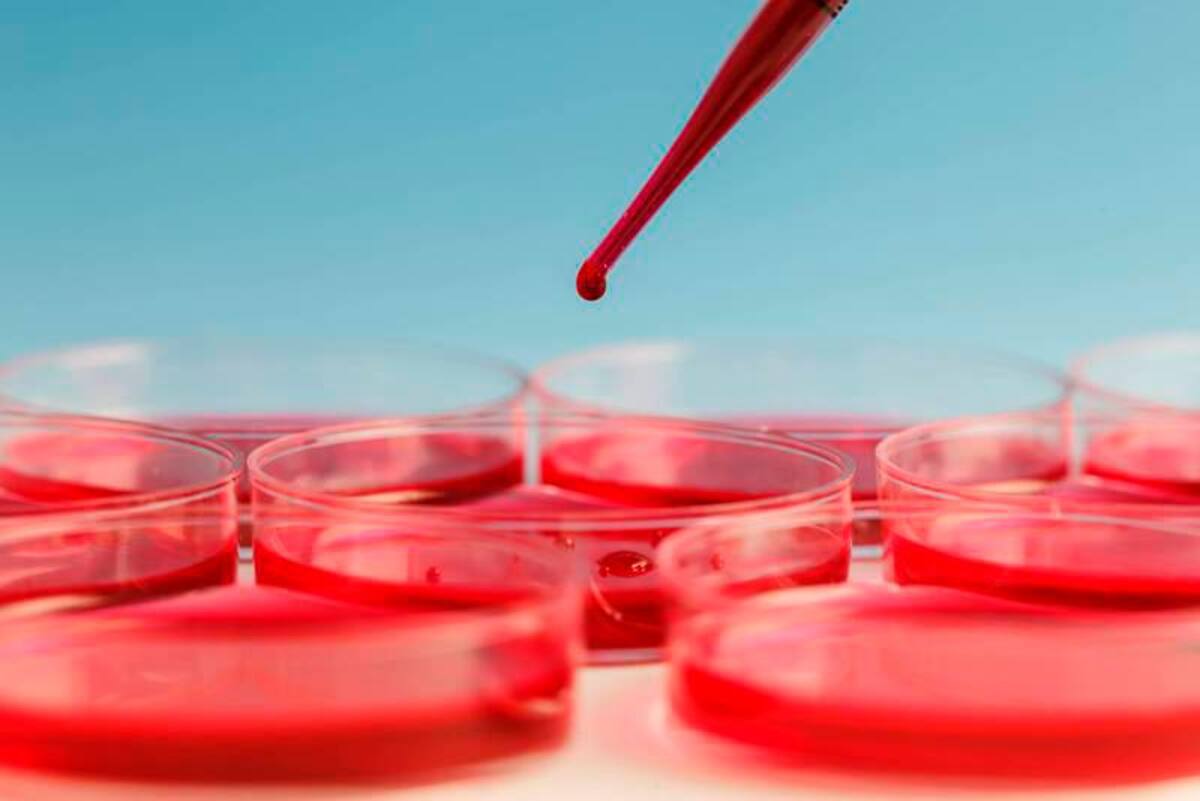

La leucemia es un tipo de cáncer de la sangre que ocurre cuando la médula ósea produce demasiados linfocitos (glóbulos blancos) inmaduros

Publicado por: Redacción Salud
Cada 4 de septiembre, el mundo une esfuerzos para conmemorar el Día Mundial de la Leucemia, un evento anual que busca aumentar la conciencia sobre esta enfermedad oncológica que afecta a la sangre y a la médula ósea.
Además: ¿Usted llena crucigramas? Estos son los beneficios para el estrés y la salud cerebral
El Día Mundial de la Leucemia nos recuerda la importancia de seguir trabajando juntos para combatir esta enfermedad a través de la investigación, la educación y el apoyo a los afectados y sus familias. Al aumentar la conciencia pública, podemos esperar avanzar hacia un futuro donde la leucemia puede ser tratada de manera más eficaz, o incluso prevenida.
En esta fecha, se busca ilustrar la gravedad de esta enfermedad, sus formas más comunes y las cifras globales de su impacto. A continuación, exploramos más detalles sobre la leucemia y la importancia de este día de concienciación.

¿Qué es la Leucemia?
La leucemia es un tipo de cáncer que se origina en las células de la médula ósea, el lugar donde se producen las células sanguíneas. Esta enfermedad lleva a una producción anormal de glóbulos blancos, que son una parte vital de nuestro sistema inmunológico.
La proliferación descontrolada de estas células puede comprometer la función de otros componentes sanguíneos, como los glóbulos rojos y las plaquetas, lo que lleva a una serie de complicaciones de salud.

Tipos más comunes de Leucemia
Existen varios tipos de leucemia, que pueden clasificarse según la velocidad de progresión y el tipo de células afectadas. Aquí están los más comunes:
Leucemia Linfoblástica Aguda (LLA): Afecta principalmente a los niños y se caracteriza por la rápida proliferación de células inmaduras llamadas linfoblastos.
Leucemia Mieloide Aguda (LMA): Es más común en adultos y también presenta una progresión rápida, afectando a las células mieloides en la médula ósea.
Leucemia Linfocítica Crónica (LLC): Predomina en los adultos mayores y tiene una progresión más lenta comparada con las formas agudas de leucemia.
Leucemia Mieloide Crónica (LMC): Afecta principalmente a los adultos y tiene una fase crónica que puede progresar a una fase aguda.

Tratamientos
Los profesionales de la salud realizarán un diagnóstico para determinar un tratamiento adecuado. Este puede incluir medicamentos o quimioterapia por vía intravenosa o intratecal (introducidos por la medula espinal), radioterapia, terapia biológica (que busca estimular o reponer el sistema inmunitario) o trasplante de médula ósea.
La leucemia es una enfermedad que afecta a personas de todas las edades en todo el mundo. Según datos globales: se estima que cada año se diagnostican cientos de miles de nuevos casos de leucemia en todo el mundo.
Además las cifras de mortalidad varían, pero se sabe que cada año fallecen decenas de miles de personas debido a complicaciones relacionadas con la leucemia.
Vea esto: ¿Cómo diferenciar la intolerancia de la alergia alimentaria? Consejos y advertencias de expertos
El 4 de septiembre se dedica a aumentar la conciencia sobre la leucemia y a promover la investigación y el desarrollo de tratamientos más eficaces. Este día también busca recordar a aquellos que han perdido la batalla contra la enfermedad y dar esperanza a los que están luchando contra ella.
Además, es una oportunidad para sensibilizar a la población sobre la importancia de la donación de médula ósea, que puede ser un tratamiento crucial para muchos pacientes con leucemia.













